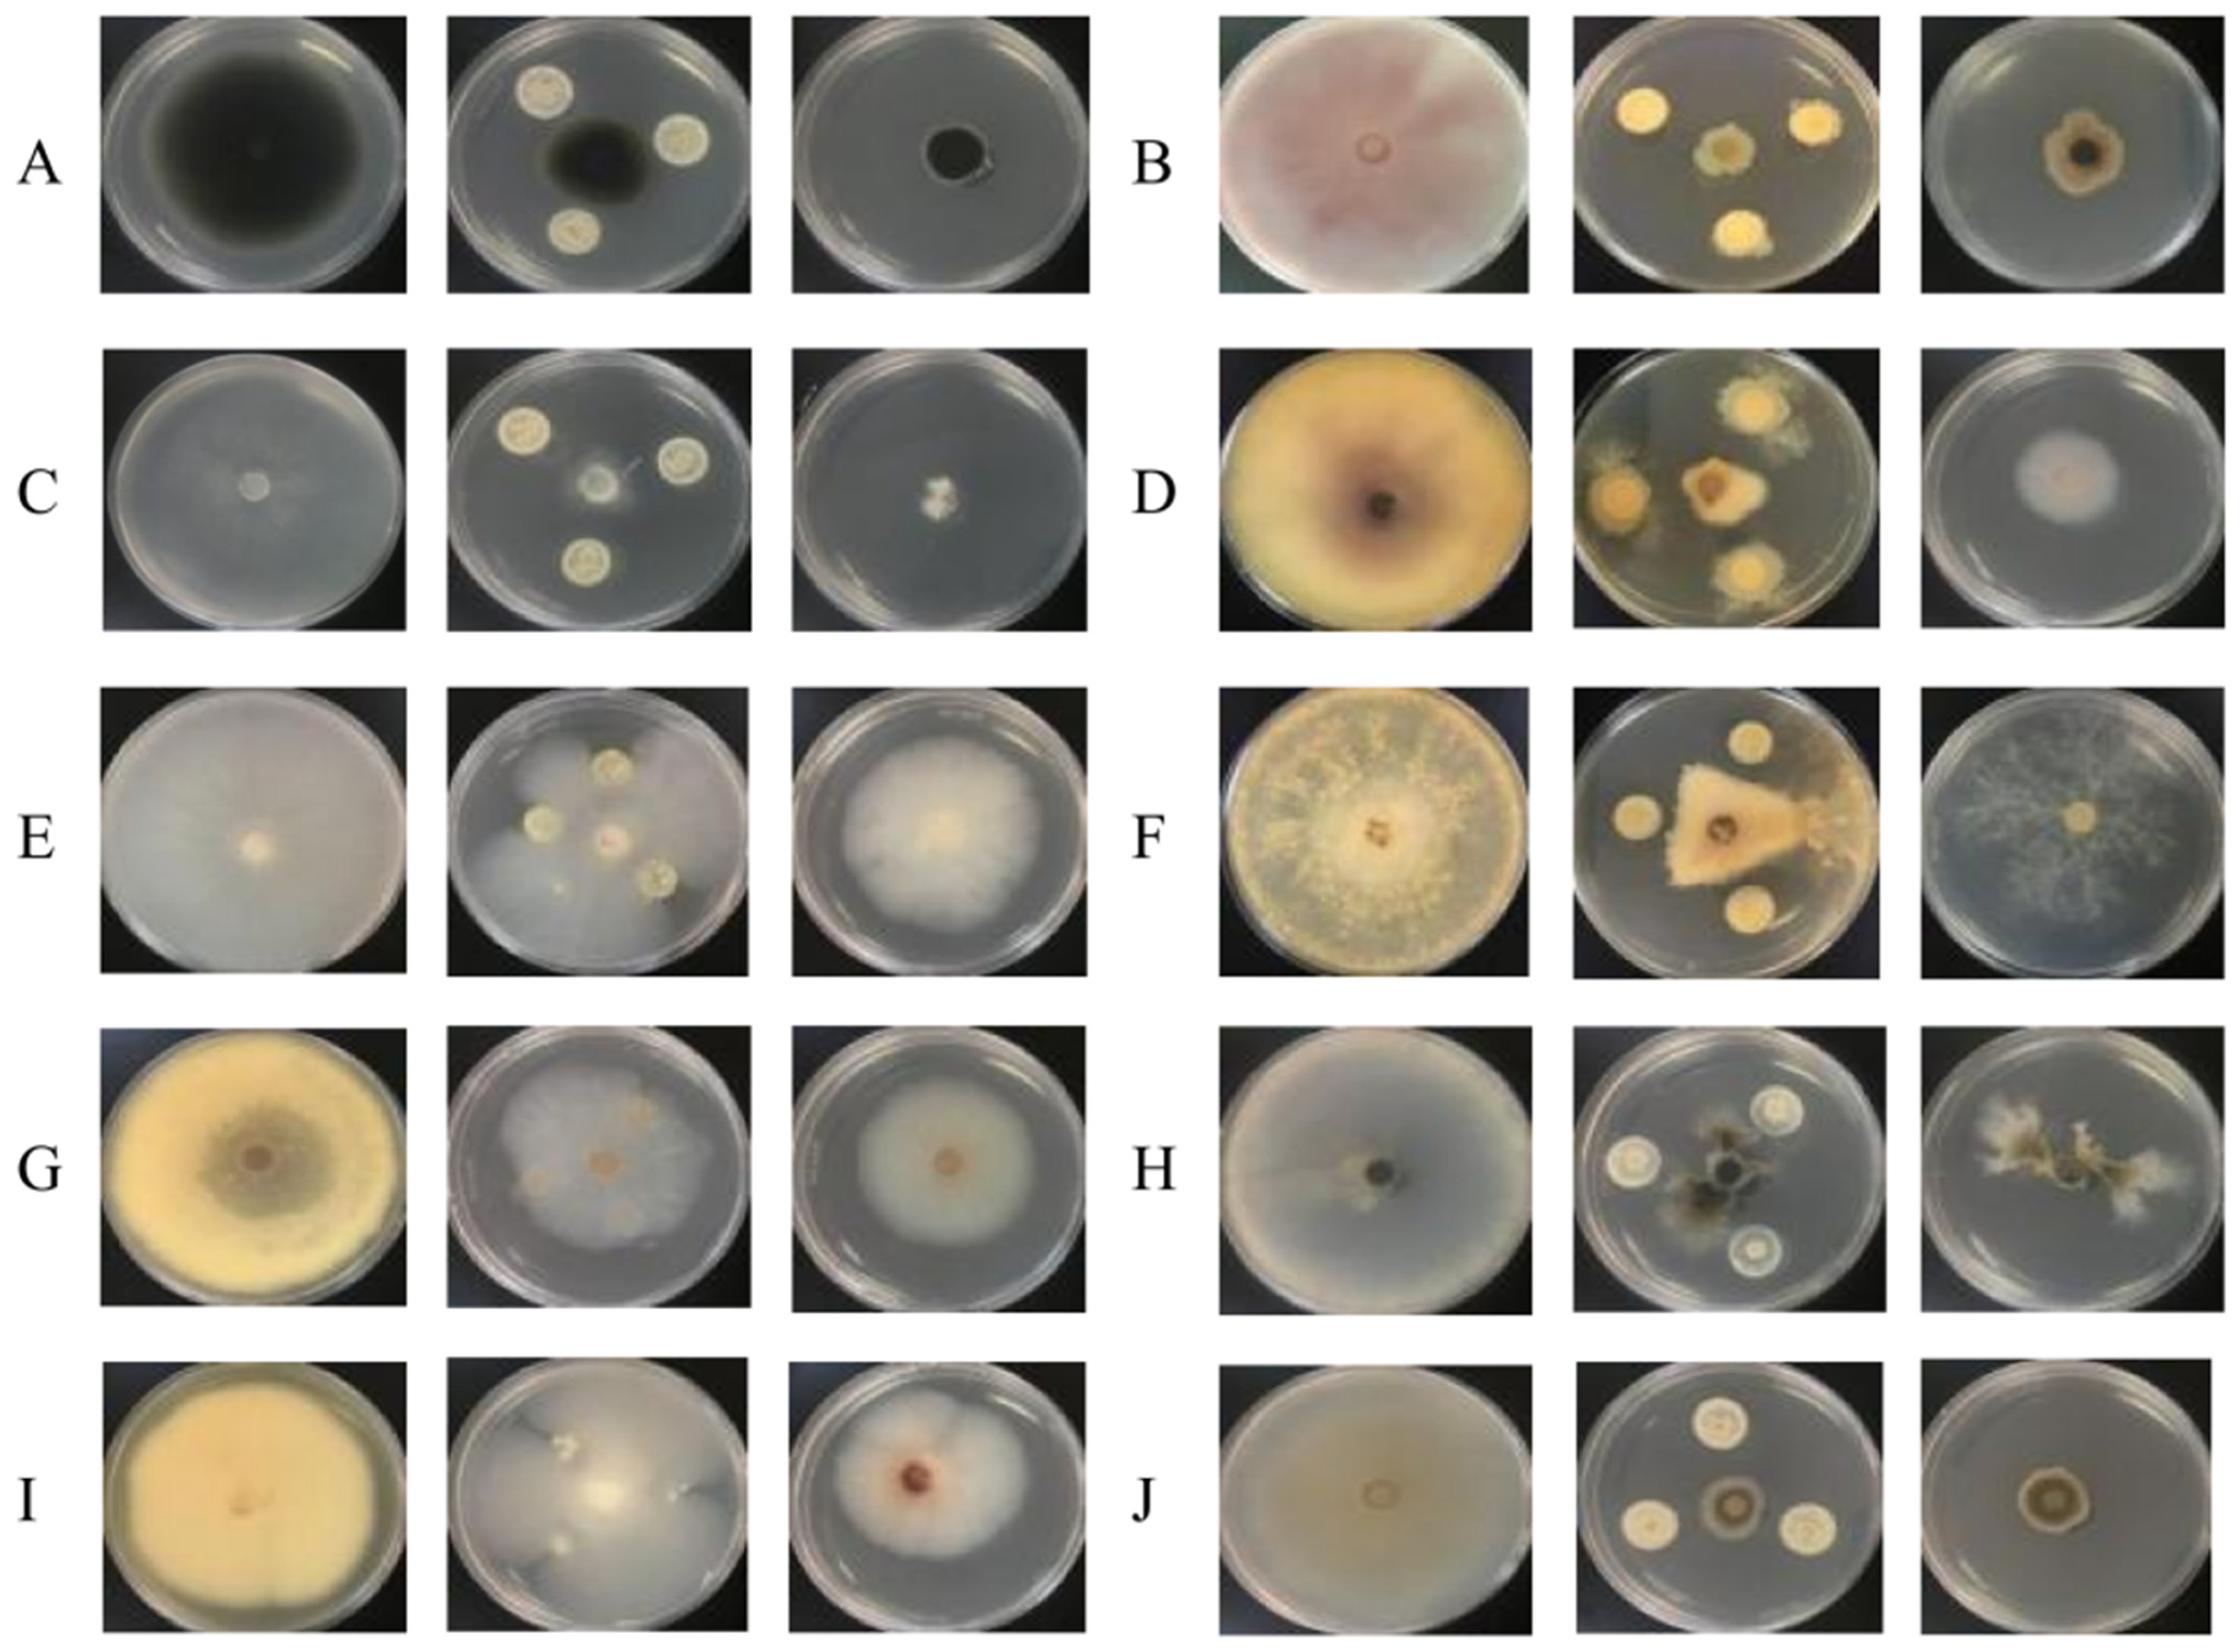
Agronomy 14 01489 g004
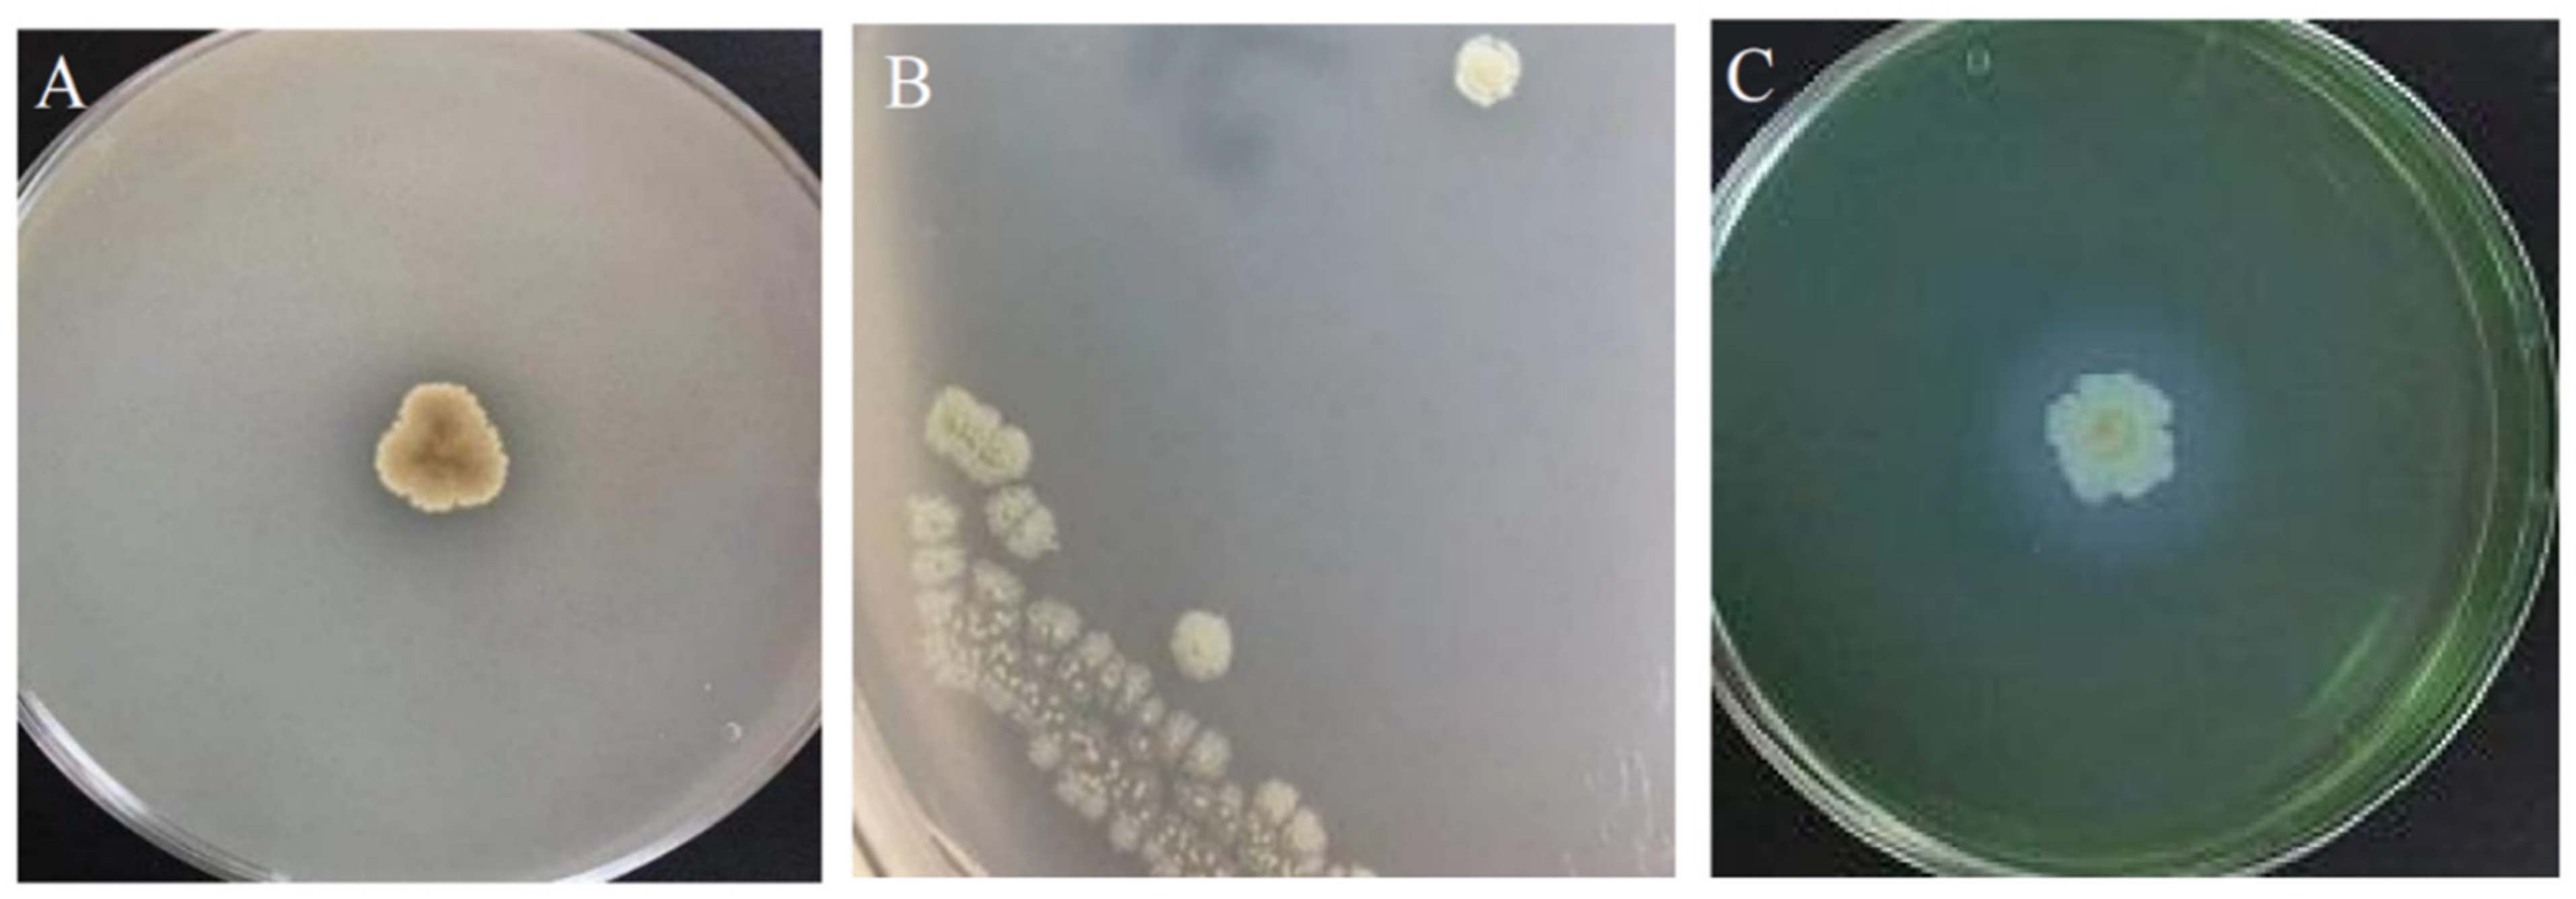
Agronomy 14 01489 g005

1. Introduction
Soil-borne diseases are one of the crucial factors preventing sustainable agriculture [
1]. These diseases, which originate from soil pathogens attacking crops through their roots or stems, represent crucial types of agricultural plant pathogens [
2]. The intricate interactions between plants, soil microorganisms, and soil pathogens exhibit mutualistic effects [
3]. The capacity of the root microbiome to generate defenses against soil pathogens by activating the plant host has been coined as root immunity [
4]. Antagonistic bacteria in the plant rhizosphere also have the characteristics of nitrogen fixation, increasing phosphorus, iron affinity, and secreting plant hormones, which provide the basic material for the establishment of beneficial bacterial resources, thereby facilitating efficient prevention and control of soil-borne plant diseases [
5,
6].
Streptomyces, belonging to the Actinomycetes family, is a Gram-positive bacterium widely distributed in soil, sea, and other natural ecological environments. It exhibits a diverse range of species and metabolic functions [
7,
8,
9].
Streptomyces can produce various antibiotics, including vincristine, wellbutrin, and wuromycin [
10], as well as other secondary metabolites with disease prevention effects, such as chitinase, cellulase, and β-1,3-glucanase [
11]. Additionally, it promotes plant growth through the secretion of indole acetic acid (IAA) [
12], siderophore [
13], phospholysis [
14], and assisting microorganisms in nitrogen fixation [
15]. Consequently,
Streptomyces serves as a pivotal strain among interroot biotrophy-promoting bacteria.
In recent years, numerous studies have identified
Streptomyces strains with antagonistic and growth-promoting properties from diverse plant rhizosphere soils, such as
Opuntia stricta [
16],
Phragmites communis [
17],
Solanum lycopersicum L. [
18],
Capsicum annuum L. [
19], and
Vitis vinifera [
20]. The obtained
Streptomyces strains can effectively induce plants to produce local or systemic resistance to fungal pathogens [
20,
21,
22]. For example, the
Streptomyces strain S37 isolated from the rhizosphere microbiome of healthy grapes can effectively induce the defense response of grapevine cells, including oxidative burst, extracellular alkalinization, protein kinase activation, induced defense gene expression, and phytoalexin accumulation, which can effectively enhance the tolerance of grape cells to pathogens [
23].
With the popularization of biocontrol technology and the update of its use methods, its application potential in the agricultural field has been further stimulated. For example, through simple soaking, injection, and other methods, biocontrol bacteria can be effectively colonized in the roots of crops to prevent or control fruit tree diseases [
24]. Screening and obtaining more
Streptomyces can effectively expand the spectrum of biocontrol bacteria and provide more options for the prevention and control of various pathogenic fungi. Therefore, the present study aimed to isolate and screen a
Streptomyces strain from the rhizosphere soil of healthy grapevine plants in severely diseased vineyards, and the antagonistic and growth-promoting effects of the strain were further evaluated to develop effective microbial biocontrol resources and provide a theoretical foundation for the biological control of soil-borne plant diseases.
2. Materials and Methods
2.1. Isolation and Identification of Streptomycete Strain
Streptomyces strains were isolated from rhizosphere soil samples collected between the roots of healthy plants in vineyards experiencing powdery mildew outbreaks at the Dongguan Agricultural Science Research Center in China (23°02′ N, 113°74′ E). Under strict aseptic conditions, 10 g of rhizosphere soil were precisely weighed and dissolved in 90 mL of sterile water. The soil–water mixture was vigorously shaken at 180 r/min for 3 h, followed by gradient dilution into 10−3, 10−4, and 10−5 suspensions. Moreover, 100 mL aliquots of each diluted suspension were uniformly dispensed onto Gao’s No. 1 medium plates and incubated at 28 °C for 7 d. Subsequently, the most optimally growing Streptomyces strain, designated F2, was identified through morphological, biochemical, and physiological characteristics, as well as Gram-staining tests. The purified culture strain was preserved in glycerol at a final concentration of 30% and stored in a freezer at −20 °C for future use.
2.2. DNA Extraction, PCR Amplification, and Sequencing for Microbial Identification
DNA extraction was performed using a standardized DNA Purification Kit (Takara, Kyoto, Japan), adhering strictly to the manufacturer’s guidelines. Subsequently, PCR amplification was performed with universal primers designed specifically for 16S rDNA, i.e., forward primer 27F (5′-AGAGTTTGATCCTGGCTCAG-3′) and reverse primer 1492R (5′-TACGGCTACCTTGTTACGACTT-3′). The PCR products were visualized and validated via 1% agarose gel electrophoresis.
Positive PCR samples were further processed by Shanghai Meiji Biomedical Technology Co., Ltd., Shanghai, China, for sequencing. The resulting sequences were then submitted to GenBank for BLAST comparison to identify closely related species. To gain further insights into the phylogenetic relationships, 16S rDNA gene sequences of closely related species within the same genus were selected and subjected to homology analysis. Finally, a phylogenetic evolutionary tree was constructed using MEGA 7.0 software.
2.3. Complete Genome Sequencing and antiSMASH Analysis
For the purpose of genome assembly, the filtered reads were assembled using the Canu v1.5 software. Subsequently, the circularization of the assembled genome was achieved by using circlator v1.5.5. In order to predict the genome components, the coding gene prediction was executed by employing the Prodigal v2.6.3 program. Following the masking of predicted functional genes, the GenBlastA v1.0.4 program was used to scan the entire genomes. Putative candidates were then subjected to analysis, focusing on the identification of non-mature and frame-shift mutations using GeneWise v2.2.0. Transfer RNA (tRNA) genes and ribosomal RNA (rRNA) were predicted using tRNAscan-SE v2.0 and Infernal v1.1.3, respectively. Additionally, repetitive sequences were anticipated using RepeatMasker. Prophage prediction was conducted with PhiSpy v2.3, and CRISPR identification was performed using CRT v1.2. For the prediction of genomic islands within the genome, IslandPath-DIMOB v0.2 was employed. Furthermore, antiSMASH v5.0.0 was used to predict secondary metabolic gene clusters, and PromPredict v1 was adopted for the prediction of promoters.
2.4. Antifungal Spectrum of F2
2.4.1. Preparation of Fermentation Broth and Sterile Filtrate for F2
To prepare the fermentation broth for F2, the strain was first inoculated into Actinomyces liquid medium and incubated at 28 °C with agitation at 130 rpm for 24 h to serve as the master batch. Subsequently, the master batch was transferred to fresh Actinomyces liquid medium, using an inoculum size of 1.5% (v/v). The strain was further incubated at 28 °C with agitation at 130 rpm for 5 d to obtain the fermentation broth. Following incubation, the fermentation broth was centrifuged at 4 °C and 9000 rpm for 20 min. The supernatant was then filtered through a 0.22 μm sterile filter membrane to yield the sterile filtrate of F2.
2.4.2. Determination of Bacterial Inhibition Spectrum of a Streptomyces Fermentation Broth
A diverse collection of plant fungal pathogens was evaluated by the plant pathology laboratory at South China Agricultural University, China (
Table 1). An in vitro assay was performed using potato dextrose agar (PDA) through antagonism bioassays. A fungal disc with a diameter of 5 mm was placed at the center of the medium, and 20 µL of
Streptomyces fermentation broth were inoculated in three evenly spaced locations, 2 cm away from the center. Plates without
Streptomyces inoculation served as controls, and each treatment was replicated three times. After incubation at 28 °C, the diameter of the fungal colony (F2) was measured from both the distal and proximal ends of the
Streptomyces inoculation site once the control colonies had fully grown on the plate. The inhibition rate of F2 against the pathogenic fungus was then calculated using the following equation:
where Dc is the average colony diameter in the control group and Dt is the average colony diameter in the treatment group.
2.4.3. Determination of Bacterial Inhibition Rate of Sterile Filtrate
The sterile filtrate of F2 was mixed with PDA medium at a 5% (
v/
v) concentration and poured onto plates at approximately 50 °C. PDA medium without the addition of the sterile filtrate was considered as the control. Fungal cakes of 5 mm in diameter were placed in the center of the mixed medium, and each treatment was replicated four times. The inhibition rate was determined as described in
Section 2.4.2.
2.5. Assay for Antagonistic and Growth-Promoting Factors
2.5.1. Determination of Phosphorus Resolution Index
Under aseptic conditions, F2 was inoculated into organophosphate bacteria and inorganic phosphorus bacteria culture medium, with three replicates of each medium. Incubation was carried out at a constant temperature of 28 °C for 7 d and observed for clear circles.
2.5.2. Determination of the Potassium Resolution Index
Under aseptic conditions, F2 was inoculated into a silicate medium using the three-zone delineation method and repeated three times. Incubation was carried out at a constant temperature of 28 °C for 7 d, and the plates of silicate bacterial medium were observed to determine whether transparent oil droplet colonies appeared.
2.5.3. Determination of Nitrogen Fixation Capacity
F2 was inoculated in the Asubet medium with sterile water as a control, and the plates were incubated at 28 °C for 7 d. The plates were considered positive if colonies were present. The nitrogen fixing enzyme activity of F2 was determined using the nitrogen fixing enzyme ELISA kit (Shanghai Xuanzekang Biological Co., Ltd., Shanghai, China).
2.5.4. Determination of the Siderophore-Producing Capacity
Under aseptic conditions, F2 was inoculated onto CAS medium plates and repeated three times. Incubation was carried out at a constant temperature of 28 °C for 7 d. The colonies were observed for the appearance of a distinct orange halo around the colonies.
2.5.5. Determination of Indole-3-Acetic Acid (IAA) Content in Fermentation Broth
After inoculating strain F2 into LB liquid medium containing 100 mg/L of tryptophan for 3 d, 2 mL of the fermentation broth was centrifuged at 4 °C and 9000 rpm for 15 min. The resulting supernatant was then extracted. Subsequently, 2 mL of Salkowski’s reagent was added to each 1 mL aliquot of the supernatant. The mixture was allowed to develop color in the dark at room temperature for 1 h, and the OD530 value was measured. Using the blank medium as the control, a standard curve was plotted with the OD530 values of standard IAA concentrations to accurately calculate the IAA content in the fermentation broth.
2.5.6. Protease Assay
Under aseptic conditions, F2 was inoculated onto the casein culture substrate and repeated three times. Incubated at a constant temperature of 28 °C for 2–5 d and observed the production of hyaline circles.
2.6. Determination of the Leaf Efficacy of the F2 Fermentation Solution against Phytophthora capsici
To prepare the F2 fermentation solution, F2 was inoculated into 150 mL of actinomycete liquid medium and incubated for 5 d at 28 °C with shaking at 130 r/min. The concentration of the solution was adjusted to 1 × 108 cfu/mL. Pepper plant leaves were selected, thoroughly washed with distilled water, disinfected with 70% alcohol for 30 s, rinsed with sterile water for 2 min, and then dried aseptically.
The disinfected pepper leaves were then soaked in the F2 fermentation solution for 1 min and placed on an ultraclean bench to dry. Each group consisted of 10 leaves, which were inoculated with 5 mm diameter mycelial blocks of Streptomyces capsici. As a control, samples were soaked in sterile water for 1 min and then inoculated with the same mycelium blocks. All leaves were cultured in a dark environment at 28 °C and 90% relative humidity.
After 4 d, the lesion diameters were measured, and the preventive effect of the F2 fermentation solution was calculated using the following formula:
where Sc is the control spot diameter and St is the treatment spot diameter.
2.7. Potted Plant Experiment
After culturing Phytophthora capsici on a PDA plate for 7 d, the mycelium was picked and soaked in sterile water, with the water being replaced every 30 min. Following the fourth water change, 10 mL of the washings were inoculated into PDB liquid medium and incubated for 5 d at 28 °C and at 180 rpm. The resulting culture was then filtered through double-sterilized gauze, and the spores were enumerated using a haemocytometer plate under a microscope. The spore suspension was diluted with sterile water to a concentration of 1 × 106 cfu × mL−1 and mixed with sterilized soil at a ratio of 1:10 to prepare pathogen-infested soil.
Pepper seedlings at the 5–6 leaf stage were then planted in the diseased soil. The plants were randomly divided the following way into three groups: the control group received 30 mL of sterile water, treatment group 2 was treated with 30 mL of 68.75% silverfali suspension (diluted 800 times), and treatment group 3 was treated with 30 mL of fermentation solution prepared according to method 1.2.5. Ten plants from each group were tested through root irrigation application. The application was repeated after 7 d, and the disease incidence was recorded at 4, 8, and 12 d days. The disease index and relative control effect were calculated using Equations (3) and (4).
The grading criteria for blast disease were as follows: Grade 0: healthy plants with no signs of disease; Grade 1: softening and wilting of heart leaves; Grade 2: wilting of 2 to 3 leaves, with leaves drooping along the base of the petiole; Grade 3: wilting and drooping of 4 to 5 leaves, with wilting of the stem tip and browning; Grade 4: wilting and drooping of 6 to 7 leaves, with wilting and browning extending from the stem tip to the upper part of the stem; and Grade 5: death of the entire plant or browning and collapse.
where r = rating value; Nr = number of diseased plants with a rating of r; Nt = total number of plants; and Hr = highest rating value.
where DIc = disease index of control group; DIt = disease index of treatment group.
2.8. Determination of the Growth-Promoting Effect of Streptomyces on Indoor Potted Peppers
The seedlings were transplanted into pots containing sterilized soil, specifically a mixture of sterilized substrate and sterilized soil at a 1:3 ratio. Subsequently, 20 mL of Streptomyces ferment solution, prepared according to the method described in
Section 2.6, was evenly poured into the soil around the roots of each plant. A control group was established, which received sterile water instead of the ferment solution. Both groups were replicated 5 times. After 7 d, the watering procedure was repeated. Fifteen days post-treatment, samples were taken to measure the root length, plant height, and fresh weight of each pepper plant.
2.9. Data Analysis
Statistical software SPSS 17.0 and Microsoft Excel 2016 were used to analyze the data. One-way ANOVA was used to test the significance of differences between treatments by the least significant difference (LSD) multiple comparison method (p = 0.05). GraphPad Prism 8 (GraphPad Software Prism 8, San Diego, CA, USA) was used to prepare graphs.
3. Results
3.1. Morphological Characteristics and Physiological and Biochemical Features of F2
Using Gao’s No. 1 medium, a well-cultivated strain F2 was isolated and purified from a grape interroot soil sample. Following seven d of incubation, the colonies exhibited a round morphology, channed from white to grey. These colonies were raised, with a velvety surface adorned with a concentric ring pattern (
Figure 1A). Microscopic observations revealed that strain F2 was a Gram-positive bacterium with spiral-shaped spore filaments and ovoid spores (
Figure 1B).
The physiological and biochemical characteristics of strain F2 are summarized in
Figure 1C. The strain demonstrated the ability to utilize D-glucose, L-arabinose, D-xylose, D-fructose, and D-mannitol as carbon sources, while showing no utilization of sucrose, rhamnose, cottonseed sugar, or inositol. Furthermore, the strain exhibited the capacity to liquefy gelatine and coagulate milk, possessed a strong starch-hydrolyzing ability, but lacked the ability to reduce nitrate and was negative for the tyrosinase reaction. DNA was extracted from strain F2 and subsequently amplified via PCR. Gel electrophoresis analysis of the amplified product revealed distinct bands (
Supplementary Materials Figure S1). Utilizing BLAST comparisons on the NCBI website, 14 strains with high homology to strain F2 were selected based on 16S rDNA sequence results. A phylogenetic tree was constructed using MEGA 7 software (
Figure 1D), which positioned strain F2 in the same branch as
Streptomyces cavourensis strain SIF3 and
Streptomyces cavourensis strain QT227.
3.2. Complete Genome Sequence and AntiSMASH Analysis of the F2 Strain
The genome features of strain F2 are summarized in
Table 1. The assembled genome was approximately 7.05 Mbp and comprises two contigs, i.e., the larger representing the chromosome, while the smaller corresponds to the plasmid. Comprehensive genome annotation has resulted in the successful prediction of 6877 sequences, encompassing both chromosomes and plasmids. Among these predicted coding sequences (CDs), 1650 were transmembrane proteins, and 658 were genes encoding secreted proteins. The position of each CDs and RNA gene was better visualized in the genome map presented in
Figure 2.
Of the 6830 genes identified, 75.05% (5126 genes) were classified under eggNOG functional categories. The distribution of these genes across various functional groups and their respective percentages are presented in
Figure 3A. Notably, the genome exhibits a significant emphasis on the transcriptional processes, with 449 proteins (8.64%) predicted to possess transcriptional activities. Additionally, 395 proteins are predicted to be involved in amino acid transport and metabolism.
Based on Nr annotations, 3334 genes, accounting for 48.85% of the total, have been annotated as homologues to genes in Streptomyces cavourensis. Moreover, according to KEGG annotations, genes are predominantly predicted to be involved in functions such as ABC transporters, amino acid biosynthesis, carbon metabolism, and purine metabolism, among others.
In this study, the whole-genome sequencing data of the isolated
Streptomyces F2 strain were analyzed using the antiSMASH platform. The resulting analysis (see
Supplementary Table S1) revealed that the strain possessed a total of 38 biosynthetic gene clusters (BGCs), signifying its robust capacity for synthesizing secondary metabolites. These BGCs were diverse, comprising 3 lanthipeptide-class-iii, 3 NI-siderophore, 14 NPRS, 2 terpene, 7 TIPKS, 3 NPRS/TIPKS, and 6 RiPP/REE clusters. Despite the abundance of BGCs in strain F2, only region 1389.1 exhibited 100% similarity with a known BGC (GenBank: AL645882.2), which is responsible for geosmin biosynthesis. This observation suggests that strain F2 has the potential to synthesize numerous additional secondary metabolites.
3.3. Inhibitory Effect of the F2 Strain on Pathogenic Fungi
The fungal inhibition spectrum of strain F2, as illustrated in
Figure 4, reveals that the strain effectively inhibited a range of fungi, including
Cercospora arachidicola Hori,
Colletotrichum falcatum,
Phytophthora capsici,
Bipolaris maydis,
Fusarium oxysporum f. sp.
cubense,
Rhizoctonia solani,
Colleterichum orbicalare,
Physalospora piricola,
Fusarium oxysporum (schl.) f.sp.
Benincasae, and
Magnaporthe oryzae, albeit to varying degrees. Notably, F2 showed the most potent inhibitory activity against
Colletotrichum falcatum Went and
Cercospora arachidicola Hori, achieving average inhibition rates of 81.59% and 80.89% for the fermentation broth and 80.58% and 87.71% for the sterile filtrate, respectively. Additionally, the F2 fermentation broth displayed inhibition rates ranging from 16.34% to 74.84% against other fungi (see
Supplementary Materials Table S2), highlighting the strain’s broad inhibition spectrum and its effectiveness against a diverse array of plant pathogens.
3.4. Determination of Growth-Promoting Factor and Antagonistic Factor
The growth-promoting and antagonistic factors of the F2 strain were assessed and illustrated in
Figure 5A–C. Notably, F2 produced diminutive, transparent circles on the organic phosphorus solution medium, indicating its capability to decompose this compound, and grew well on the asbestos medium (
Figure 5A). Furthermore,
Streptomyces F2 grew well in Ashube medium, exhibiting a nitrogenase activity of 173.4 U/L, thereby demonstrating its nitrogen-fixing ability (
Figure 5B). On the casein medium, a transparent ring with a diameter of 22–24 mm was observed around the colony (
Figure 5C). The measurement of the IAA content revealed a value of 9.62 mg/mL. Collectively, these experimental results suggest that F2 possesses a certain proficiency in decomposing organic phosphorus, fixing nitrogen, secreting extracellular protease, and producing IAA.
3.5. Determination of Control Effect of Fermentation Broth against Phytophthora Disease of P. capsici
After 4 d of inoculation with
P. capsici mycelium blocks on pepper leaves soaked in sterile water, large black lesions were observed, resulting in the leaves becoming limp and necrotic (
Figure 6A). However, when the pepper leaves were soaked in the F2 fermentation broth prior to inoculation, the incidence of disease was substantially reduced, and the leaves retained a higher degree of freshness (
Figure 6B). Specifically, the lesion areas on leaves treated with the F2 fermentation broth and sterile water were 43.553 ± 4.74 cm
2 and 142.738 ± 12.56 cm
2, respectively (
Figure 6C).
3.6. Field Control Effect of F2 on Pepper P. capsica
Figure 7 shows the efficacy of
Streptomyces F2 fermentation liquid in managing
Phytophthora capsici in indoor potted capsicum plants. Notably, the utilization of this fermentation liquid through root irrigation significantly reduced the disease index of pepper blight compared to the control treatment with sterile water. Specifically, on the 4th, 8th, and 12th d post-inoculation, the control effects achieved were 67.88%, 83.31%, and 73.67%, respectively.
In contrast to the conventional chemical agent Yinfali, Streptomyces F2 fermentation liquid exhibited a more rapid initial effect, attaining a control efficacy of 90.55% within 4 d of application. However, the sustained effectiveness of Yinfali was inferior to that of the fermentation broth of strain F2, exhibiting a control effect of 66.02% after 12 d.
Furthermore, this study investigated the stimulatory effects of Streptomyces F2 fermentation liquid on the growth of indoor potted capsicum plants. Remarkably, root irrigation with the fermentation broth of strain F2 significantly enhanced plant growth. Following treatment, the root length, plant height, and fresh weight of the pepper plants were 23.14 ± 1.25 cm, 34.79 ± 2.56 cm, and 18.11 ± 1.77 g/plant, respectively. These values represent increments of 46.74%, 61.33%, and 59.76% compared to the control plants, indicating a positive impact on pepper growth.
4. Discussion
The rhizosphere, a unique ecological niche, encompasses the interplay between plants, soil, and microorganisms. This interaction involves biochemical exchanges, the transmission of signaling molecules, nutrient transformation, gene exchange, and the release of root exudates [
25,
26]. Actinomycetes, a significant microbial group in soil, particularly thrive in the rhizosphere [
27]. The present study focuses on the rhizosphere soil of healthy plants in a vineyard contaminated with pathogenic bacteria. Herein, we isolated and characterized
Streptomyces sp. strain F2 (
Figure 1), which possesses inhibitory activity against diverse pathogenic bacteria (
Figure 4). Furthermore, this strain can synthesize the plant hormone indoleacetic acid (IAA), fix atmospheric nitrogen, and dissolved phosphate (
Figure 5).
As an excellent strain with broad-spectrum antagonistic effects,
Streptomyces sp. has a wide range of sources. Recently, several studies have isolated
Streptomyces sp. strains from diverse environments and examined their antagonistic properties, fermentation conditions, and methods for purifying active ingredients [
24]. Pan et al. [
28] conducted research on the marine-derived
S. cavourensis strain NA4, reporting the first time that
S. cavourensis produces bafilomycin B1 and C1. These compounds displayed significant inhibitory activities against a variety of
Fusarium species and
Alternaria solani, but no activity was observed against
Exserohilum turcicum. Yang et al. [
29] screened
S. cavourensis TJ430, exhibiting remarkable broad-spectrum antifungal activity, and isolated a novel bafemycin from TJ430 organisms. Fatma et al. [
30] isolated
Streptomyces sp. from Tunisian soil contaminated with industrial wastewater, exhibiting potent antibacterial activity against Gram-negative and Gram-positive bacteria, as well as fungi. Employing various chromatographic techniques, they identified seven biological compounds in the strain extracts. Similarly, in this study, the F2 strain exhibited notable control effects against pepper
phytophthora and other pathogenic bacteria (
Figure 6), suggesting its significant potential for applications. Additionally, we reported the growth-promoting effects of
Streptomyces sp. The F2 strain possesses phosphorus-solubilizing activity and can produce IAA and other biomass-promoting substances. Phosphorus-solubilization enhances plant growth and yield, improves nutrient availability, produces phytohormones, and supports plant growth under abiotic stress (
Figure 7). These attributes are crucial for sustainable agriculture and reducing environmental pollution caused by chemical fertilizers and pesticides [
31].
For decades,
Streptomyces species have been a rich source of bioactive natural products, medicinal chemicals, and innovative drugs [
32]. Nevertheless, in recent years, the advancement of novel drug research and development (R&D) technologies, along with diminishing funding for traditional drug R&D avenues, has led to a gradual reduction in studies focused on
Streptomyces and its active ingredients [
33]. If not revived by novel bioinformatics techniques and methodologies, such as genome mining, this downward trend could impede efforts to utilize
Streptomyces as a source of novel bioactive substances. Conservative estimates indicate that the genus has the potential to synthesize over 150,000 additional antimicrobial compounds beyond those currently known, suggesting that
Streptomyces remains an untapped resource [
34,
35].
The use of new bioinformatics technologies and methods, particularly genome sequencing, can facilitate more precise classification of target strains and provide deeper insights into their antibiotic metabolism and other functionalities. These approaches have been widely used in
Streptomyces identification. For instance, Hoyos et al. [
36] isolated a strain of
S. cavourensis 1AS2a exhibiting robust antibacterial activity from the rhizosphere of wheat in the Brazilian Neotropical grassland. Analysis of the strain’s complete genome sequence revealed a total genome length of 7,600,475 base pairs (bp), encompassing 6590 open reading frames (ORFs). This analysis also identified 30 biosynthesis-related gene clusters (BGCs), providing a genetic foundation for further research into the strain’s potential to produce antibacterial compounds. The sequencing results of this study over showed that the total genome length of the F2 strain was 7,049,055 base pairs (bp), and 6877 sequences were successfully annotated (
Table 1). In the functional analysis, 395 proteins were predicted to be involved in amino acid transport and metabolic processes (
Figure 3).
The tool, antiSMASH, stands as the foremost extensively utilized platform for mining biosynthesis-related gene clusters (BGCs) pertaining to secondary/specialized metabolites (SMs) in microbial genomes [
37]. Cruz-Morales et al. [
38] have documented the presence of efficacious secondary metabolites, such as siderophores, in
Streptomyces sp. CC77. Additionally, Nguyen et al. [
39] isolated
S. cavuolii YBQ59 from the root of cinnamon, a medicinal plant indigenous to Vietnam, and subsequently purified eight distinct pure secondary metabolites from the culture medium. Upon analyzing the draft genome sequence, it was revealed that this strain can produce the antibiotic bafemycin D, among others. With regard to antibiotics, a total of 14 gene clusters were found to be associated with antibiotic biosynthetic pathways. Notably, in the outcomes of the antiSMASH analysis conducted in this study, only one terpene-like gene cluster exhibited homology with known clusters in the MIBiG database (
Table S1), suggesting that the majority of the secondary metabolites produced by the F2 strain remain unknown. It can be inferred that the secondary metabolites synthesized by this strain harbor unknown active ingredients, thereby meriting further exploration.